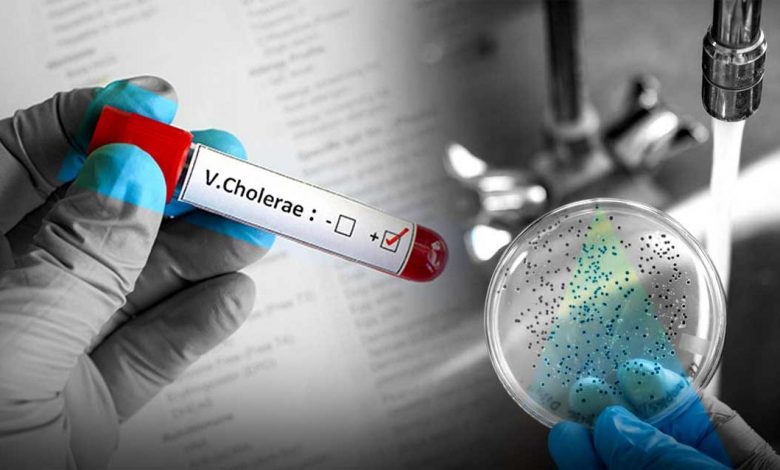

Solo uno de los once pacientes con diarrea aguda en Barahna dio positivo por cólera, informó Salud Pública.
Santo Domingo. Solo uno de los once pacientes sospechosos enojo adentro no seas grande Prueba positiva para bacterias, los diez restantes solo están presentes diarrea severa, Informe Ministerio de Salud PúblicaDio positivo para Vibrio cholerae serogrupo 01, serotipo Ogawa, según los resultados del Laboratorio Nacional Dr. DiFilo.
paciente positivo la enfermedad Pelti Renetta, de 25 años, quien ingresó la tarde del lunes 10 de julio con síntomas de diarrea acuosa y fluida.
seis salud pública Es decir, estable y después de la recepción. tratamiento Se tomaron las muestras respectivas.
El grupo de once estaba ingresado en el Hospital Jaime Mota y el Hospital Enriquillo en la provincia de Barahona.
La entidad indicó que otros pacientes fueron dados de alta y se encuentran estables, continuando tratamiento relacionado con su diarrea, pues también presentaron otros patógenos como Shigella, Salmonella, Ascaris lumbricoides y Estamoida encontrados en los resultados de laboratorio oficiales.
Y anuncio La organización indicó que, “Luego de un bloqueo epidemiológico conjunto con la Dirección Provincial de Salud de Barahona y la Dirección de Gestión de Riesgos del MSP, a la fecha no se reportan otros pacientes con síntomas sospechosos de diarrea en esta comunidad”.



